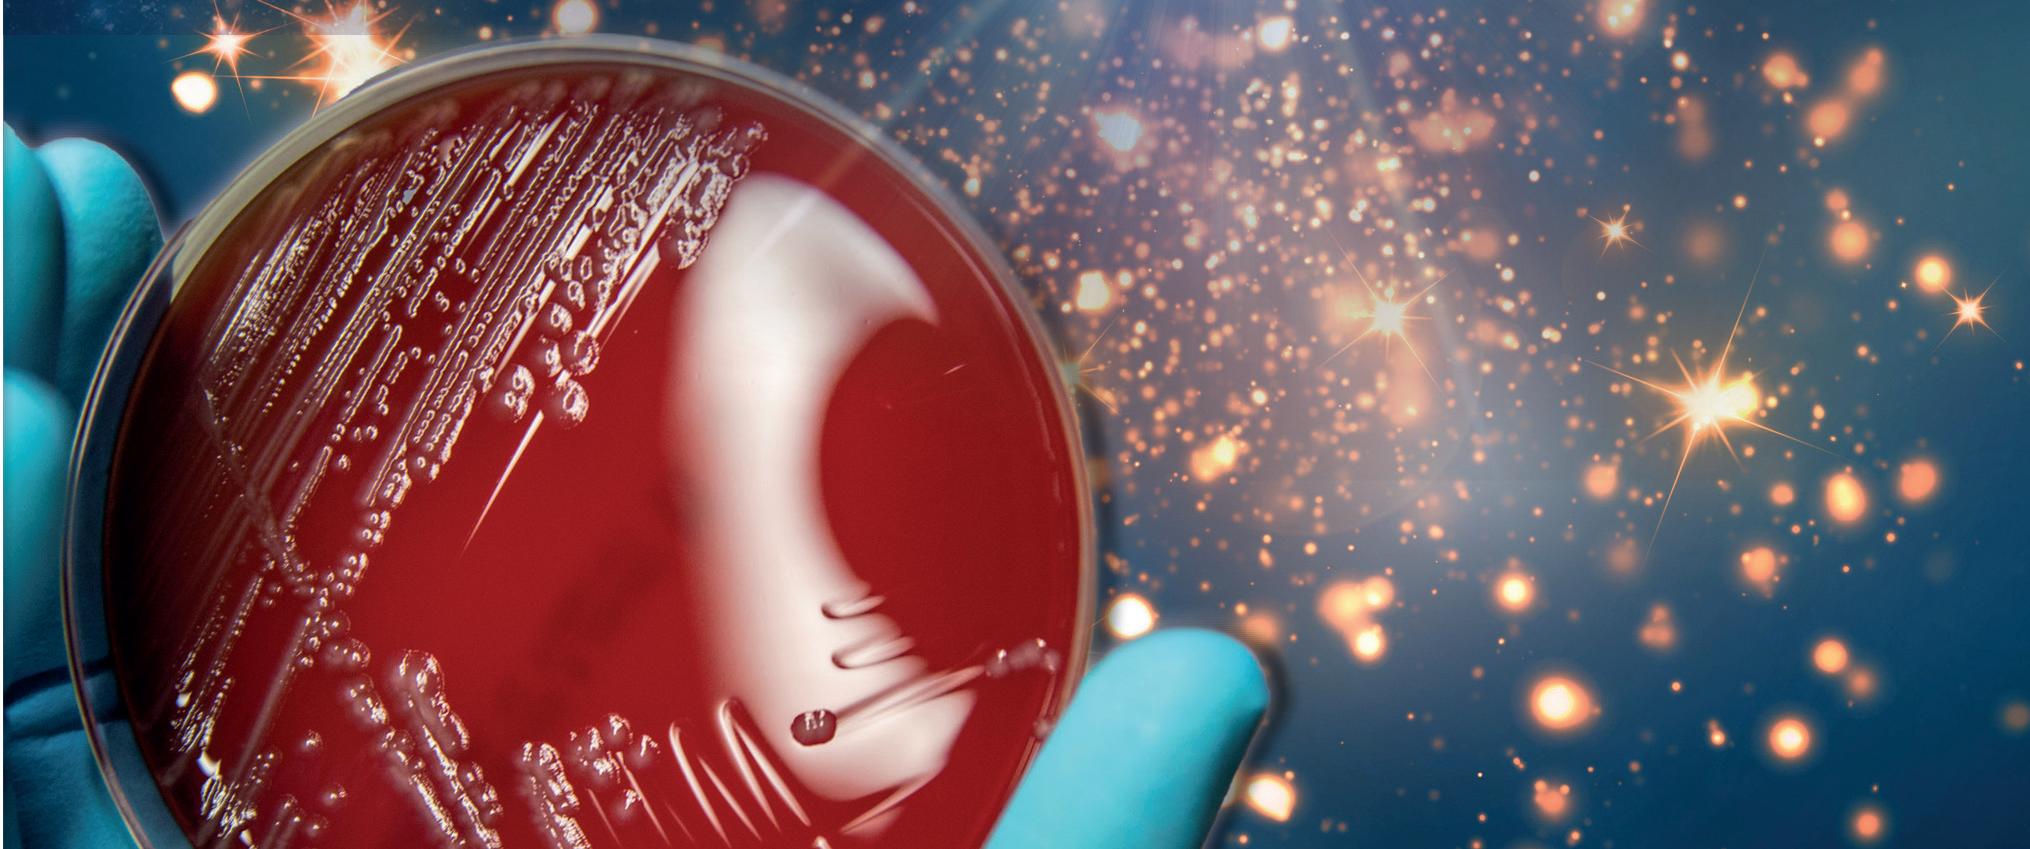

13 minute read
Southern Community Laboratories
Moving forward to meet an increasingly digitalised and consolidated healthcare sector, we take a look at Southern Community Laboratories and speak to Peter Gootjes, CEO, about the company’s latest developments
Writer: Marcus Kääpä | Project Manager: Callam Waller
NEW INVESTMENT, NEW ZEALAND
After gaining a medical degree I sought to work in a managerial position within the healthcare sector. I obtained qualifications in medical management, including hospital management, and was then invited to apply for a role at a pathology firm. 27 years later I have moved through several positions, such as business development manager, and now I am CEO of the company; one of the bigger medical diagnostic groups in New Zealand, in an industry that I love.”

Peter Gootjes, CEO of Southern Community Laboratories (SCL), has spent his life amid medical experts collectively bettering the healthcare sector of New Zealand for almost three decades. SCL exists as a company under the wider Asia Pacific Healthcare Group (APHG). In contrast to its position in the present day, SCL began as a small private pathology service in the South Island city of Dunedin in the 1960s. Since then, its operations have progressively expanded to become part of New Zealand’s largest network of diagnostic laboratories, providing medical services over most of the country.
“Our laboratories offer a wide range of diagnostic tests in biochemistry, haematology, microbiology, immunology, molecular pathology, histology and cytology,” Gootjes informs us. “They are equipped with the newest analysers and state-ofthe-art computer systems. Most of our routine patient test results are reported back to the requesting doctors within 24 hours of specimen collection.”
SCL VALUES
SCL is committed to the future of pathology in New Zealand through excellence in technical, clinical, and service innovations. As a member of APHG, the company operates under the following STAR values:
SERVICE EXCELLENCE:
• Striving to provide the highest standard of health care • Looking for new opportunities and ways to improve care and services • Seeking to understand and exceed expectations
TEAMWORK AND INTEGRITY:
• SCL’s employees know they can rely on their team • Openness and honesty in all communications between staff • Encouraging constructive feedback and recognising achievements
ASPIRATION:
• SCL looks to the future, always ensuring that it has stable platforms from which to build • Continuous learning and creativity are integral to the team, their jobs and the success of the company • SCL is proactive and innovative in response to new and emerging industry and community opportunities and needs
RESPONSIBILITY:
• Team members are accountable to their colleagues, clients and stakeholders, the company and the shareholders • SCL’s decisions are made with a balanced focus on financial security and service excellence • Services are delivered in a way that incorporates the principles of
Treaty of Waitangi and acknowledges cultural diversity
BD
BD is proud to partner with Southern Community Labs across the diagnostic pathway from patient collection through to quality lab testing, enabling New Zealand’s clinicians to provide fast and accurate diagnosis.
BD is a trusted supplier to SCL as we share the same values of quality, innovation and improving patient care.
BD currently provides our high quality blood collection, microbiology and cytology solutions to SCL and is ready to deliver new innovative molecular testing platforms across New Zealand for HPV screening.
For more information visit our website below.
www.bd.com/en-au
Cepheid
Cepheid has been a trusted business partner of SCL and is a leading on-demand molecular diagnostics company that is dedicated to improving healthcare by developing fully-integrated systems and accurate yet easy-to-use molecular tests.
The company is focusing on applications where rapid and actionable test results are needed most, in fields such as critical and healthcare-associated infections, sexual health, genetic diseases and cancer.
For more information, please visit us online at:
www.cepheidinternational.com

LEADING THE WAY IN NZ
SCL places its company focus on providing top-quality laboratory services for health professionals and their patients, and the company has branches in smaller provincial towns as well as larger cities across New Zealand.
“SCL has grown from its earlier days roughly 60 years ago to be one of the largest laboratory companies in the country,” Gootjes says. “Nation-wide we work with 18 laboratories and 82 collection rooms, providing services to GPs and specialists in the private sector, as well as services to public hospitals.
“We have always been run by medical experts and we make sure that we understand the wants and needs of our customers and those they serve. We visit and talk with them to ensure that we know exactly what they need so that we can answer that demand, and I believe that these close-knit relationships make SCL stand out in the sector.”
DEVELOPING HEALTHCARE
On top of accommodating the specific needs of its customers in the medical field, SCL sees an important advantage in the investment of the latest technologies, IT innovations and business improvements to not only maintain an edge in the sector but also pave the way for progressive and new aspects of business in healthcare. Quick off-the-mark to develop COVID-19 testing, cost and operational efficiencies, and listening to its own staff are existing business elements that make SCL a leading company in New Zealand. This progressive mindset has been a relatively new aspect of SCL, as Gootjes elaborates.
“There was a trend in the 1990s for restructuring of the healthcare sector in New Zealand,” he reflects. “This was almost continuous restructuring that stopped around the year 2000 until last year.
“There has been a recent movement forwards when it comes to restructuring the industry, and this has been very smooth because COVID19 has not impacted the country as much as in many other countries; the virus has been handled incredibly well through border control, vaccines and our natural sea barriers, and as such has not been a major event for the sector. But with regards to
Fort Richard Laboratories
For Southern Community Laboratories, results are everything. Partnering with industry-leaders Fort Richard, lab professionals trust they will always have the right products on hand, so they can deliver results in time-critical situations.
With over 50 years experience, Fort Richard Laboratories understands workflows and processes within a lab, and brings quality products and technical advice to the Southern Community team when it’s needed quickly. Fort Richard’s microbiologists also assist with product evaluation and training.
Responsive service and reliable supply has been vital to the laboratory and procurement teams during the COVID-19 pandemic.
www.fortrichard.com
Hygiene Systems
Hygiene Systems operates in both Australia and New Zealand. We distribute and provide essential hygiene products andservices.
As a leader in our industry, we commit to providing excellent hygiene protection whilst maintaining cost and waste efficiency with our innovative controlled dispensing systems. With Hoop 247 our online support platform, full servicing team, and local hygiene consultants, we make sure each customer’s specific requirements are taken care of.
Visit our website or call us to book a free online hygiene consultation.
New Zealand | 0800 367 494
Australia | 07 3801 8500
hygienesystems.com.au
restructuring, the country is moving towards a single centralised system under which all government funded healthcare will be based.”
This national healthcare system will operate with a central body across New Zealand, and fittingly, SCL is internally incorporating a microcosmic version of such a system.
“The two major companies under APHG, of which SCL is one, operate on two different systems that are separated and individual,” Gootjes explains. “We are currently undergoing a major project to align these systems and bring everything, spanning both companies, under one umbrella system that will increase ease, efficiency and make processes much smoother and fluid”.
INVESTING IN HEALTHCARE
It is no surprise that digitalisation is at the forefront of development efforts for companies across the globe. With COVID-19 having fasttracked the implementation and necessity of the latest technologies and online software and services, the healthcare sector, both internationally and in New Zealand, has recognised the importance and operational advantage of utilising digital means.
Within this space, SCL has placed a heavy focus on the digital sphere, its innovative offers, and how these can bring operational fluidity to present healthcare in the country.
“Traditionally in the healthcare sector people write medical letters or print out forms to take to hospitals
QUALITY ACCREDITATION
SCL holds accreditation against ISO 15189:2012 as a medical testing laboratory service.
IANZ is the organisation that makes sure New Zealand keeps being the kind of place people love living in. The organisation protects the health and wealth of New Zealand by ensuring that those who test or inspect the products and services people buy, consume, use, or are surrounded by every day are safe, accurate, and are not doing harm. The organisation undertakes this by ensuring testing laboratories, inspection bodies, building consent authorities and medical imaging providers meet international standards and can demonstrate that they are competent.
IANZ also helps SCL’s exporters access international markets by ensuring that those who test or inspect its products, meet the required standards for each country. Not all laboratories or inspection bodies are accredited, so when you see that company reports or certificates carry the IANZ mark of competence, customers can have confidence in results that are trusted in New Zealand and around the world.
WHAT IS ISO 15189:2012?
ISO 15189:2012 is an international standard for competence and quality in medical laboratories. It is applied by the International Organisation for Standardisation (ISO).
HOW ARE SCL ACCREDITED?
Internal Accreditation New Zealand (IANZ) runs annual assessments to test SCL’s quality system’s compliance with the standard.
Radiometer
At Radiometer our focus is on fast, accurate diagnostic solutions for acute care, including Blood Gas, Hemocue and AQT immunoassay for cardiac, coagulation, sepsis and pregnancy stat testing.
AQURE middleware supports our Total care solution with transmission of patient results and remote Laboratory control of operators and quality standards.
Our New Zealand team of four specialist staff offers training and support for 120 instruments across New Zealand, backed by reliable consumables and spares from our Auckland Warehouse.
Radiometer’s partnership with SCL extends back to 2006, with more than 90% of SCL sites choosing Radiometer.
www.radiometer.com.au
RICOH New Zealand Limited
Accounts Payable automation is often described as low hanging fruit in the garden of digital transformation. And for a good reason – the barrier to entry is impressively low in terms of both cost and effort.
The value provided from AP automation is comparably high. For such an easy implementation, the benefits reach throughout an organization, beyond the walls of the AP department.
You can see them from day one of using the solution, providing fast, accurate processes with real time reporting to manage your cashflow and compliance.
www.ricoh.co.nz/ap

Science Directions Limited
Science Directions Limited, the Bruker Mass Spectrometry partner in New Zealand has worked closely with Southern Community Laboratories (APHG) for several years, supplying and supporting the world leading Bruker MALDI Biotyper® (MBT) systems in their laboratories.
MBT systems enable microbiology laboratories to reliably and rapidly identify microbes, in a cost-effective manner. Allowing unbiased identification of microorganisms within a few minutes down to the species level, the MBT is an easy, rapid, robust, high-throughput, costeffective and efficient identification technology, ideally suited to clinical, food safety and environmental microbiology laboratories.
www.bruker.com/microbiology
or the other medical institutions,” Gootjes explains. “In order to reduce this inefficiency, we have taken action to move on to electronic orders, known as ‘e-orders’.
“Clients now send through orders digitally; forms that remain on record online with the reduced chance for human error both regarding information and the stored location of such forms. This really eliminates the prospect of mistakes and slow processes, and SCL is currently one of the leading members using such e-orders.”
Alongside this, SCL is looking towards genetic sequencing as a service that comes in particularly useful when considering medical fields such as oncology and the related identification of genetic hereditary cancers. In fields such as this, genetic sequencing becomes an invaluable tool to invest in to help highlight genetic mutations and hereditary issues many people may face. APAC OUTLOOK: CAN YOU TELL US ABOUT THE
RELATIONSHIP BETWEEN SCL AND ITS PARTNERS AND SUPPLIERS?

Peter Gootjes, CEO: “The industry is full of key multinational players, and we work with a lot of them. The closer you work with suppliers the more you each gain from it, and the more you appreciate the business.
“Europe and the US are home to most of the medical suppliers that we work with, and most of the chemicals and analysers that we use come from these areas as well. Our suppliers and the supply chain in general are very good and reliable to work with, and they look after us very well.
“We have managed to continue operating throughout COVID-19 and look forward to a future of continued excellent partnerships as we move forward in the sector. The supply chain has had a few problems during COVID-19 but overall we have managed very well.”
MALDI Biotyper® sirius System
The sirius Solution for Your Microbial Identifi cations
• Microorganism identifi cation within minutes • Accuracy comparable to nucleic acid sequencing • Positive ion mode for classical proteomic analysis for your identifi cations • Positive ion mode for classical proteomic analysis for your identifi cations (IVD-CE, US-IVD, RUO, GP) • Negative ion mode for lipidomic analysis in advanced applications (RUO and GP mode only) • 200 Hz smartbeam™ lifetime laser and integrated ion source cleaning • 200 Hz smartbeam™ lifetime laser and integrated ion source cleaning • High capacity vacuum system • True benchtop system
Please contact your local representative for availability in your country. For New Zealand please contact info@sciencedirections.com
www.bruker.com/microbiology | info.md@bruker.com

Innovation with Integrity
MALDI-TOF
“And digital pathology is another area of investment for us,” Gootjes tells us. “Where classically pathologists would look at glass slides on a microscope to view tissue samples, we are undertaking a project to set up across all of our sites a digitalised version of this that improves the overall process.
“This involves running the slides through a scanner and producing a digital image that provides many obvious advantages; images can be sent digitally for further medical opinions, or primary diagnostics can be displayed on computer screens. I believe that it is the way of the future, and SCL is investing significantly into implementing this technology.”
Each of these projects and investments are SCL’s way of maintaining streamlined processes in the present and into the future, a core aim of the company for the years ahead.
THE CORE OF SCL
When it comes to its employees, SCL recognises the importance of experts in the business. The company itself is home to 1,200 members of staff while the wider APHG group is made up of 2,000. For Gootjes the people of SCL are the reason the company has grown so successfully over the recent decade.
“We do our best to look after our staff, and this is returned with a very loyal core of long serving employees,” he assures us. “We run annual awards to celebrate the exceptional service of individuals, and we also run engagement surveys to ensure that we gain feedback to see what our employees need, what they want, and what they think of the company and how we operate.
“Company training systems are also present, and we aim to improve and develop our staff through this company training. In-house management training courses are something that we have recently been running, which is a very good way to produce management personnel who innately understand our systems and have knowledge on how best to run them. Staff are our major asset and make up half of our company cost structure, so we invest to try to retain these staff as much as possible and keep them happy.
“At the centre of SCL we have a great team of people that keep things going.”

Tel: 0800 101 444 or 03 470 2919 www.sclabs.co.nz